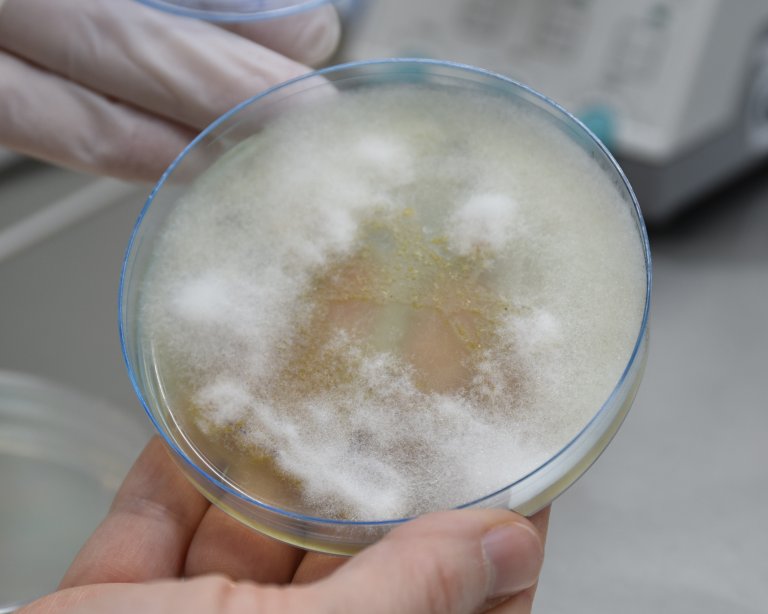
Faktaside Saprolegnia_Foto_Mari M Press.jpg

Saprolegniose
Saprolegniose er en sykdom hos fisk, amfibier og rogn i ferskvann, der årsaka er eggsporesopp i slekten Saprolegnia.
Smittestoff og smitteveier
Arter innen slekten Saprolegnia (Saprolegniaceae, Oomycota) er regnet for å være saprofytter som bryter ned dødt organisk materiale. Enkelte arter er likevel i stand til å infisere fisk og rogn. Det er særlig Saprolegnia parasitica som er assosiert med sykdom hos fisk, mens Saprolegnia diclina er det største problemet på rogn. Andre Saprolegnia-arter blir også isolerte fra syk fisk og rogn, men er ikke like patogene. Saprolegnia-arter finnes til vanlig i de fleste ferskvannskilder og sprer seg ved hjelp av rørlige sporer, såkalte zoosporer. Klekkeri og settefiskanlegg kan dermed bli smitta via inntaksvannet. Sporene er relativt hardføre, og vanlig ferskvannsbehandling, som UV-filter og ozonbehandling, er ikke tilstrekkelig effektive til eliminering.
Videre er det vist at Saprolegnia spp. har evne til å produsere sporer i rør og karsystem i settefiskanlegg uten at infeksjon er påvist hos fisk eller rogn, trolig ved å danne eller delta i biofilm og ved å benytte seg av sedimentert organisk materiale som substrat. Dette vil kunne gi et betydelig økt smittepress.
Eggsporesoppen er normalt avhengig av at fiskens immunsystem er nedsatt for at infeksjonen skal utvikle seg, for eksempel ved stress, eller at fisken har skader i slimlag og hud.
På rogn under inkubering må det finnes døde egg for at saprolegniose skal kunne etable seg.
Sykdomstegn
Saprolegniose har trolig vært kjent i flere hundre år på grunn av det lett gjenkjennelige hvite belegget (mycelet) som blir dannet på infisert fisk.
Infeksjon på fisk starter som oftest på områder som ikke er dekket av skjell, særlig på hode/gjellelokk, og sprer seg så langs ryggen til fettfinnen og ved finnebasis. I affiserte områder sprer infeksjonen seg ved hyfevekst i epidermis, dermis og hypodermis, og kan i alvorlige tilfeller trenge ned i underliggende muskelvev.
Degenerative forandringer og nekroser i huden reduserer fiskens evne til osmoregulering og kan i alvorlige tilfeller føre til at fisken dør. Ved infeksjon på gjeller blir respirasjonen hemmet og fisken kan dø av «kvelning». De siste årene kan det se ut som at Saprolegnia har vært mer patogene enn tidligere.
Sporene greier ikke å etablere infeksjon på levende rognkorn. De etablerer seg likevel på døde rognkorn og annet dødt materiale. Fra denne infeksjonen utvikler det seg hyfer, og disse sprer seg til levende rognkorn i nærheten og penetrerer og dreper disse. Infeksjonen sprer seg slik fra egg til egg, og kan sees som et ullent slør som omslutter de rammede eggene.
Diagnostikk
Diagnosen saprolegniose blir vanligvis stilt på grunnlag av makroskopisk synlige lesjoner.
Veterinærinstituttet diagnostiserer saprolegniose og artsidentifiserer agens (Saprolegnia spp.) ved hjelp av dyrking og DNA-sekvensering.
Forekomst
I norsk oppdrett av laksefisk har saprolegniose stort sett vært et problem på egg under inkubering, selv om en har sett utbrudd på yngel og parr, særlig i etterkant av vaksinering. I andre land som driver med akvakultur av laksefisk, som Chile, Canada og Skottland, blir det rapportert om betydelige økonomiske tap på grunn av saprolegniose. En kan finne infeksjonen gjennom hele ferskvannsfasen.
På villfisk er saprolegniose spesielt lagt merke til på kjønnsmoden fisk i og rundt gytetid, ved spesielle tilfelle av miljøpåvirkning, stress og annen sykdom, for eksempel parasittangrep. I oppdrett ser en infeksjoner gjennom ferskvannsfasen, men også på stamfisk som blir overført til ferskvann før stryking. Første kjente skildring av (eggspore)soppinfeksjon på en vertebrat kom i 1748 av Arderon som beskrev det som mest trolig var saprolegniose på en mort.
Tiltak
Sykdommen ble inntil år 2000 effektivt forebygd og kontrollert med det organiske fargestoffet malakittgrønt. Dette stoffet ble deretter forbudt brukt i akvakultur på grunn av kreftfremkallende egenskaper, først i USA og etter hvert i resten av verden. Dette forbudet har ført til at saprolegniose igjen har blitt et problem fordi det per i dag ikke finnes alternative behandlingsmiddel som er like effektive.
Formalin er det mest kostnadseffektive middelet som er brukt i dag, og det vil i de fleste tilfeller være førstevalget i kampen mot et utbrudd. Men bruken av formalin i akvakultur er også omdiskutert og er for tiden oppe til vurdering i EU-systemet. Det kan dermed bli innført avgrensninger eller forbud mot bruk av formalin mot parasitter og eggsporesopp på fisk i løpet av få år. Der blir derfor ekstra viktig å fokusere på forebyggende tiltak.
Viktige forebyggende tiltak er å unngå å stresse fisken unødvendig og å behandla den så skånsomt som mulig i situasjoner der håndtering er nødvendig, som ved sortering, flytting og vaksinering. Det er også viktig å holda generelt god hygiene og vannkvalitet for å unngå oppformering av sporer i anleggets vannsystem. For rogn under inkubering og i klekkeperioden er det viktigeste forebyggende tiltaket å fjerne død rogn og ofte fjerne rester av organisk materiale.
